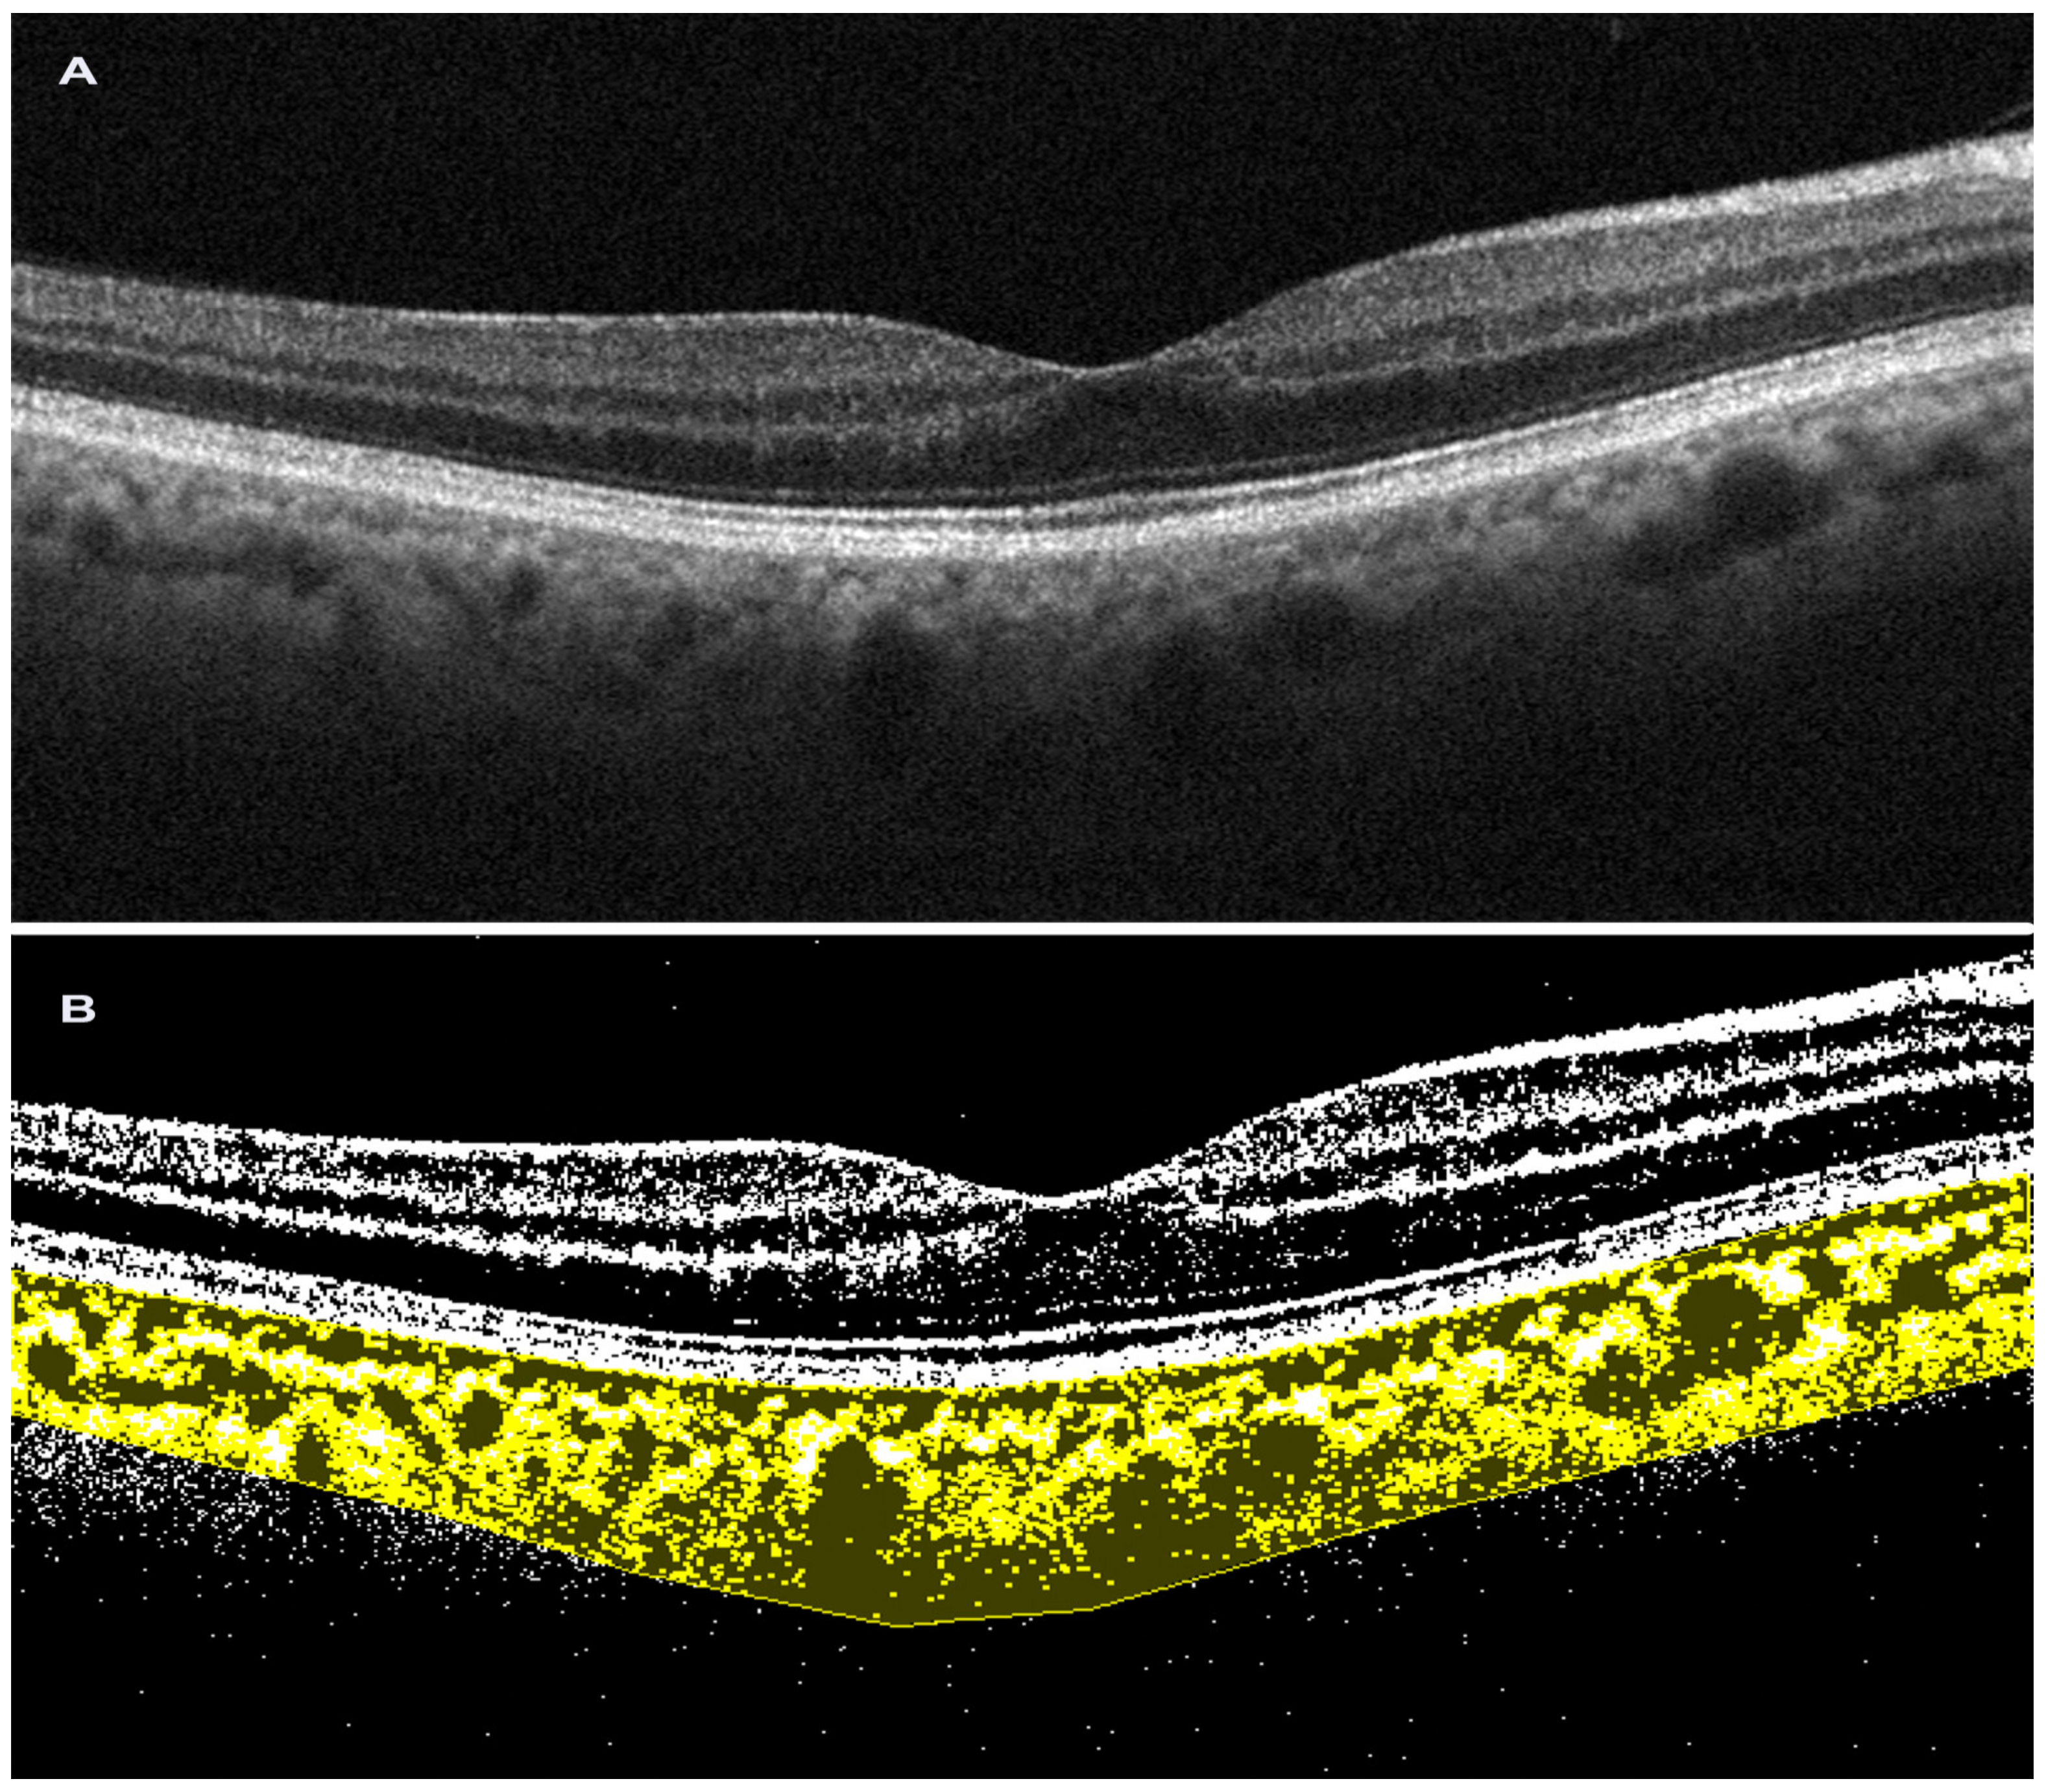
Tomography 09 00116 g002 Tomography 09 00116 g002

The Choroidal Vascularity Index Versus Optical Coherence Tomography Angiography in the Evaluation of the Choroid with a Focus on Age-Related Macular Degeneration
Abstract
1. Introduction
2. Choroidal Parameters
2.1. Anatomy of Choroid
2.2. SDOCT
2.3. Choroidal Thickness
2.4. Choroidal Vascularity Index
2.5. Optical Coherence Tomography Angiography
3. Test Results for Age-Related Macular Degeneration
3.1. CVI in AMD
3.2. OCTA in AMD
4. Conclusions
Author Contributions
Funding
Institutional Review Board Statement
Informed Consent Statement
Data Availability Statement
Conflicts of Interest
References
- Nickla, D.L.; Wallman, J. The Multifunctional Choroid. Prog. Retin. Eye Res. 2010, 29, 144–168. [Google Scholar] [CrossRef] [PubMed]
- Chhablani, J.; Barteselli, G. Clinical Applications of Choroidal Imaging Technologies. Indian J. Ophthalmol. 2015, 63, 384–390. [Google Scholar] [CrossRef] [PubMed]
- Ferrara, D.; Waheed, N.K.; Duker, J.S. Investigating the Choriocapillaris and Choroidal Vasculature with New Optical Coherence Tomography Technologies. Prog. Retin. Eye Res. 2016, 52, 130–155. [Google Scholar] [CrossRef] [PubMed]
- Kashani, A.H.; Chen, C.-L.; Gahm, J.K.; Zheng, F.; Richter, G.M.; Rosenfeld, P.J.; Shi, Y.; Wang, R.K. Optical Coherence Tomography Angiography: A Comprehensive Review of Current Methods and Clinical Applications. Prog. Retin. Eye Res. 2017, 60, 66–100. [Google Scholar] [CrossRef]
- Agrawal, R.; Gupta, P.; Tan, K.-A.; Cheung, C.M.G.; Wong, T.-Y.; Cheng, C.-Y. Choroidal Vascularity Index as a Measure of Vascular Status of the Choroid: Measurements in Healthy Eyes from a Population-Based Study. Sci. Rep. 2016, 6, 21090. [Google Scholar] [CrossRef] [PubMed]
- Lejoyeux, R.; Benillouche, J.; Ong, J.; Errera, M.-H.; Rossi, E.A.; Singh, S.R.; Dansingani, K.K.; da Silva, S.; Sinha, D.; Sahel, J.-A.; et al. Choriocapillaris: Fundamentals and Advancements. Prog. Retin. Eye Res. 2022, 87, 100997. [Google Scholar] [CrossRef]
- Pichi, F.; Aggarwal, K.; Neri, P.; Salvetti, P.; Lembo, A.; Nucci, P.; Gemmy Cheung, C.M.; Gupta, V. Choroidal Biomarkers. Indian J. Ophthalmol. 2018, 66, 1716–1726. [Google Scholar] [CrossRef]
- Bill, A.; Sperber, G.; Ujiie, K. Physiology of the Choroidal Vascular Bed. Int. Ophthalmol. 1983, 6, 101–107. [Google Scholar] [CrossRef]
- Olver, J.M. Functional Anatomy of the Choroidal Circulation: Methyl Methacrylate Casting of Human Choroid. Eye 1990, 4 Pt 2, 262–272. [Google Scholar] [CrossRef]
- Fryczkowski, A.W.; Sherman, M.D. Scanning Electron Microscopy of Human Ocular Vascular Casts: The Submacular Choriocapillaris. Acta Anat. 1988, 132, 265–269. [Google Scholar] [CrossRef]
- Krebs, W.; Krebs, I.P. Ultrastructural Evidence for Lymphatic Capillaries in the Primate Choroid. Arch. Ophthalmol. 1988, 106, 1615–1616. [Google Scholar] [CrossRef] [PubMed]
- Formisano, M.; di Pippo, M.C.; Scuderi, L.; Abdolrahimzadeh, S. Current Concepts on Diffuse Choroidal Hemangioma in Sturge Weber Syndrome. Ophthalmic Genet. 2021, 42, 375–382. [Google Scholar] [CrossRef] [PubMed]
- Di Pippo, M.; Ciancimino, C.; Scuderi, L.; Perdicchi, A. An Iconic Case of Pigmentary Glaucoma: Brief Review of the Literature. Case Rep. Ophthalmol. 2020, 11, 377–384. [Google Scholar] [CrossRef]
- Ko, T.H.; Fujimoto, J.G.; Schuman, J.S.; Paunescu, L.A.; Kowalevicz, A.M.; Hartl, I.; Drexler, W.; Wollstein, G.; Ishikawa, H.; Duker, J.S. Comparison of Ultrahigh- and Standard-Resolution Optical Coherence Tomography for Imaging Macular Pathology. Ophthalmology 2005, 112, 1922.e1–1922.e15. [Google Scholar] [CrossRef]
- Schuman, S.G.; Koreishi, A.F.; Farsiu, S.; Jung, S.; Izatt, J.A.; Toth, C.A. Photoreceptor Layer Thinning over Drusen in Eyes with Age-Related Macular Degeneration Imaged In Vivo with Spectral Domain Optical Coherence Tomography. Ophthalmology 2009, 116, 488–496.e2. [Google Scholar] [CrossRef]
- Eandi, C.M.; De Geronimo, D.; Giannini, D.; Polito, M.S.; Tosi, G.M.; Neri, G.; Le Mer, Y.; Varano, M.; Parravano, M. Baseline SD-OCT Characteristics of Diabetic Macular Oedema Patterns Can Predict Morphological Features and Timing of Recurrence in Patients Treated with Dexamethasone Intravitreal Implants. Acta Diabetol. 2020, 57, 867–874. [Google Scholar] [CrossRef]
- De Bats, F.; Wolff, B.; Mauget-Faÿsse, M.; Scemama, C.; Kodjikian, L. B-Scan and “En-Face” Spectral-Domain Optical Coherence Tomography Imaging for the Diagnosis and Followup of Acute Retinal Pigment Epitheliitis. Case Rep. Med. 2013, 2013, e260237. [Google Scholar] [CrossRef] [PubMed]
- Wolff, B.; Matet, A.; Vasseur, V.; Sahel, J.-A.; Mauget-Faÿsse, M. En Face OCT Imaging for the Diagnosis of Outer Retinal Tubulations in Age-Related Macular Degeneration. J. Ophthalmol. 2012, 2012, 542417. [Google Scholar] [CrossRef]
- Spaide, R.F.; Koizumi, H.; Pozzoni, M.C. Enhanced Depth Imaging Spectral-Domain Optical Coherence Tomography. Am. J. Ophthalmol. 2008, 146, 496–500. [Google Scholar] [CrossRef]
- Moult, E.; Choi, W.; Waheed, N.K.; Adhi, M.; Lee, B.; Lu, C.D.; Jayaraman, V.; Potsaid, B.; Rosenfeld, P.J.; Duker, J.S.; et al. Ultrahigh-Speed Swept-Source OCT Angiography in Exudative AMD. Ophthalmic. Surg. Lasers Imaging Retin. 2014, 45, 496–505. [Google Scholar] [CrossRef]
- Corvi, F.; Pellegrini, M.; Erba, S.; Cozzi, M.; Staurenghi, G.; Giani, A. Reproducibility of Vessel Density, Fractal Dimension, and Foveal Avascular Zone Using 7 Different Optical Coherence Tomography Angiography Devices. Am. J. Ophthalmol. 2018, 186, 25–31. [Google Scholar] [CrossRef]
- Zhang, Q.; Chen, C.-L.; Chu, Z.; Zheng, F.; Miller, A.; Roisman, L.; Rafael de Oliveira Dias, J.; Yehoshua, Z.; Schaal, K.B.; Feuer, W.; et al. Automated Quantitation of Choroidal Neovascularization: A Comparison Study between Spectral-Domain and Swept-Source OCT Angiograms. Investig. Ophthalmol. Vis. Sci. 2017, 58, 1506–1513. [Google Scholar] [CrossRef] [PubMed]
- Corvi, F.; Cozzi, M.; Barbolini, E.; Nizza, D.; Belotti, M.; Staurenghi, G.; Giani, A. Comparison between several optical coherence tomography angiography devices and indocyanine green angiography of choroidal neovascularization. Retina 2020, 40, 873–880. [Google Scholar] [CrossRef] [PubMed]
- Coleman, D.J.; Lizzi, F.L. In Vivo Choroidal Thickness Measurement. Am. J. Ophthalmol. 1979, 88, 369–375. [Google Scholar] [CrossRef]
- Abdolrahimzadeh, S.; Scavella, V.; Battaglia, D.; Recupero, S.M. Spectral Domain Optical Coherence Tomography of Choroidal and Outer Retinal Layer Thickness in the Sturge Weber Syndrome. Curr. Eye Res. 2016, 41, 1614–1617. [Google Scholar] [CrossRef]
- Abdolrahimzadeh, S.; Di Pippo, M.; Ciancimino, C.; Di Staso, F.; Lotery, A.J. Choroidal Vascularity Index and Choroidal Thickness: Potential Biomarkers in Retinitis Pigmentosa. Eye 2022, 37, 1766–1773. [Google Scholar] [CrossRef]
- Kim, Y.H.; Oh, J. Choroidal Thickness Profile in Chorioretinal Diseases: Beyond the Macula. Front. Med. 2021, 8, 797428. [Google Scholar] [CrossRef] [PubMed]
- Mrejen, S.; Spaide, R.F. Optical Coherence Tomography: Imaging of the Choroid and Beyond. Surv. Ophthalmol. 2013, 58, 387–429. [Google Scholar] [CrossRef]
- Abdolrahimzadeh, S.; Parisi, F.; Scavella, V.; Recupero, S.M. Optical coherence tomography evidence on the correlation of choroidal thickness and age with vascularized retinal layers in normal eyes. Retina 2016, 36, 2329–2338. [Google Scholar] [CrossRef]
- Margolis, R.; Spaide, R.F. A Pilot Study of Enhanced Depth Imaging Optical Coherence Tomography of the Choroid in Normal Eyes. Am. J. Ophthalmol. 2009, 147, 811–815. [Google Scholar] [CrossRef]
- Gharbiya, M.; Giustolisi, R.; Marchiori, J.; Bruscolini, A.; Mallone, F.; Fameli, V.; Nebbioso, M.; Abdolrahimzadeh, S. Comparison of Short-Term Choroidal Thickness and Retinal Morphological Changes after Intravitreal Anti-VEGF Therapy with Ranibizumab or Aflibercept in Treatment-Naive Eyes. Curr. Eye Res. 2018, 43, 391–396. [Google Scholar] [CrossRef] [PubMed]
- Jiang, X.; Xiao, P.; Tan, Q.; Zhu, Y. Variation of Choroidal Thickness during the Waking Period over Three Consecutive Days in Different Degrees of Myopia and Emmetropia Using Optical Coherence Tomography. PeerJ 2023, 11, e15317. [Google Scholar] [CrossRef] [PubMed]
- Fragiotta, S.; Scuderi, L.; Iodice, C.M.; Rullo, D.; Di Pippo, M.; Maugliani, E.; Abdolrahimzadeh, S. Choroidal Vasculature Changes in Age-Related Macular Degeneration: From a Molecular to a Clinical Perspective. Int. J. Mol. Sci. 2022, 23, 12010. [Google Scholar] [CrossRef] [PubMed]
- Tan, K.-A.; Gupta, P.; Agarwal, A.; Chhablani, J.; Cheng, C.-Y.; Keane, P.A.; Agrawal, R. State of Science: Choroidal Thickness and Systemic Health. Surv. Ophthalmol. 2016, 61, 566–581. [Google Scholar] [CrossRef] [PubMed]
- Keenan, T.D.; Klein, B.; Agrón, E.; Chew, E.Y.; Cukras, C.A.; Wong, W.T. Choroidal thickness and vascularity vary with disease severity and subretinal drusenoid deposit presence in nonadvanced age-related macular degeneration. Retina 2020, 40, 632–642. [Google Scholar] [CrossRef] [PubMed]
- Sonoda, S.; Sakamoto, T.; Yamashita, T.; Uchino, E.; Kawano, H.; Yoshihara, N.; Terasaki, H.; Shirasawa, M.; Tomita, M.; Ishibashi, T. Luminal and Stromal Areas of Choroid Determined by Binarization Method of Optical Coherence Tomographic Images. Am. J. Ophthalmol. 2015, 159, 1123–1131.e1. [Google Scholar] [CrossRef] [PubMed]
- Sonoda, S.; Sakamoto, T.; Yamashita, T.; Shirasawa, M.; Uchino, E.; Terasaki, H.; Tomita, M. Choroidal Structure in Normal Eyes and after Photodynamic Therapy Determined by Binarization of Optical Coherence Tomographic Images. Investig. Ophthalmol. Vis. Sci. 2014, 55, 3893–3899. [Google Scholar] [CrossRef] [PubMed]
- Abdolrahimzadeh, S.; Fragiotta, S.; Ciacimino, C.; Di Pippo, M.; Scuderi, G. Choroidal Vascularity Index in Adult-Onset Foveomacular Vitelliform Dystrophy: A Pilot Study. Appl. Sci. 2021, 11, 10487. [Google Scholar] [CrossRef]
- Oh, J.; Baik, D.J.; Ahn, J. Inter-Relationship between Retinal and Choroidal Vasculatures Using Optical Coherence Tomography Angiography in Normal Eyes. Eur. J. Ophthalmol. 2020, 30, 48–57. [Google Scholar] [CrossRef]
- Iovino, C.; Pellegrini, M.; Bernabei, F.; Borrelli, E.; Sacconi, R.; Govetto, A.; Vagge, A.; Di Zazzo, A.; Forlini, M.; Finocchio, L.; et al. Choroidal Vascularity Index: An In-Depth Analysis of This Novel Optical Coherence Tomography Parameter. J. Clin. Med. 2020, 9, 595. [Google Scholar] [CrossRef]
- Ruiz-Medrano, J.; Ruiz-Moreno, J.M.; Goud, A.; Vupparaboina, K.K.; Jana, S.; Chhablani, J. Age-related changes in choroidal vascular density of healthy subjects based on image binarization of swept-source optical coherence tomography. Retina 2018, 38, 508–515. [Google Scholar] [CrossRef] [PubMed]
- Singh, S.R.; Rasheed, M.A.; Goud, A.; Sahoo, N.K.; Vupparaboina, K.K.; Chhablani, J. Diurnal Variation in Subfoveal and Peripapillary Choroidal Vascularity Index in Healthy Eyes. Indian J. Ophthalmol. 2019, 67, 1667–1672. [Google Scholar] [CrossRef] [PubMed]
- Ting, D.S.W.; Yanagi, Y.; Agrawal, R.; Teo, H.Y.; Seen, S.; Yeo, I.Y.S.; Mathur, R.; Chan, C.M.; Lee, S.Y.; Wong, E.Y.M.; et al. Choroidal Remodeling in Age-Related Macular Degeneration and Polypoidal Choroidal Vasculopathy: A 12-Month Prospective Study. Sci. Rep. 2017, 7, 7868. [Google Scholar] [CrossRef] [PubMed]
- Agrawal, R.; Seen, S.; Vaishnavi, S.; Vupparaboina, K.K.; Goud, A.; Rasheed, M.A.; Chhablani, J. Choroidal Vascularity Index Using Swept-Source and Spectral-Domain Optical Coherence Tomography: A Comparative Study. Ophthalmic Surg. Lasers Imaging Retin. 2019, 50, e26–e32. [Google Scholar] [CrossRef] [PubMed]
- Zhang, M.; Hwang, T.S.; Campbell, J.P.; Bailey, S.T.; Wilson, D.J.; Huang, D.; Jia, Y. Projection-Resolved Optical Coherence Tomographic Angiography. Biomed. Opt. Express 2016, 7, 816–828. [Google Scholar] [CrossRef]
- Betzler, B.K.; Ding, J.; Wei, X.; Lee, J.M.; Grewal, D.S.; Fekrat, S.; Sadda, S.R.; Zarbin, M.A.; Agarwal, A.; Gupta, V.; et al. Choroidal Vascularity Index: A Step towards Software as a Medical Device. Br. J. Ophthalmol. 2022, 106, 149–155. [Google Scholar] [CrossRef]
- Agrawal, R.; Ding, J.; Sen, P.; Rousselot, A.; Chan, A.; Nivison-Smith, L.; Wei, X.; Mahajan, S.; Kim, R.; Mishra, C.; et al. Exploring Choroidal Angioarchitecture in Health and Disease Using Choroidal Vascularity Index. Prog. Retin. Eye Res. 2020, 77, 100829. [Google Scholar] [CrossRef]
- Spaide, R.F.; Fujimoto, J.G.; Waheed, N.K.; Sadda, S.R.; Staurenghi, G. Optical Coherence Tomography Angiography. Prog. Retin. Eye Res. 2018, 64, 1–55. [Google Scholar] [CrossRef]
- Spaide, R.F.; Fujimoto, J.G.; Waheed, N.K. Image artifacts in optical coherence tomography angiography. Retina 2015, 35, 2163–2180. [Google Scholar] [CrossRef]
- Coscas, G.; Lupidi, M.; Coscas, F. Image Analysis of Optical Coherence Tomography Angiography. Dev. Ophthalmol. 2016, 56, 30–36. [Google Scholar] [CrossRef]
- Hamada, M.; Ohkoshi, K.; Inagaki, K.; Ebihara, N.; Murakami, A. Visualization of Microaneurysms Using Optical Coherence Tomography Angiography: Comparison of OCTA En Face, OCT B-Scan, OCT En Face, FA, and IA Images. Jpn. J. Ophthalmol. 2018, 62, 168–175. [Google Scholar] [CrossRef]
- Sohrab, M.; Wu, K.; Fawzi, A.A. A Pilot Study of Morphometric Analysis of Choroidal Vasculature in Vivo, Using En Face Optical Coherence Tomography. PLoS ONE 2012, 7, e48631. [Google Scholar] [CrossRef] [PubMed]
- Choi, W.; Mohler, K.J.; Potsaid, B.; Lu, C.D.; Liu, J.J.; Jayaraman, V.; Cable, A.E.; Duker, J.S.; Huber, R.; Fujimoto, J.G. Choriocapillaris and Choroidal Microvasculature Imaging with Ultrahigh Speed OCT Angiography. PLoS ONE 2013, 8, e81499. [Google Scholar] [CrossRef] [PubMed]
- Spaide, R.F. Peau d’orange and Angioid Streaks: Manifestations of Bruch Membrane Pathology. Retina 2015, 35, 392–397. [Google Scholar] [CrossRef] [PubMed]
- Motaghiannezam, R.; Schwartz, D.M.; Fraser, S.E. In Vivo Human Choroidal Vascular Pattern Visualization Using High-Speed Swept-Source Optical Coherence Tomography at 1060 Nm. Investig. Ophthalmol. Vis. Sci. 2012, 53, 2337–2348. [Google Scholar] [CrossRef] [PubMed]
- Spaide, R.F. Optical Coherence Tomography Angiography Signs of Vascular Abnormalization with Antiangiogenic Therapy for Choroidal Neovascularization. Am. J. Ophthalmol. 2015, 160, 6–16. [Google Scholar] [CrossRef]
- Spaide, R.F. Choriocapillaris Flow Features follow a Power Law Distribution: Implications for Characterization and Mechanisms of Disease Progression. Am. J. Ophthalmol. 2016, 170, 58–67. [Google Scholar] [CrossRef]
- Braaf, B.; Vermeer, K.A.; Vienola, K.V.; de Boer, J.F. Angiography of the Retina and the Choroid with Phase-Resolved OCT Using Interval-Optimized Backstitched B-Scans. Opt. Express 2012, 20, 20516–20534. [Google Scholar] [CrossRef][Green Version]
- Choi, W.; Moult, E.M.; Waheed, N.K.; Adhi, M.; Lee, B.; Lu, C.D.; de Carlo, T.E.; Jayaraman, V.; Rosenfeld, P.J.; Duker, J.S.; et al. Ultrahigh-Speed, Swept-Source Optical Coherence Tomography Angiography in Nonexudative Age-Related Macular Degeneration with Geographic Atrophy. Ophthalmology 2015, 122, 2532–2544. [Google Scholar] [CrossRef]
- Tokayer, J.; Jia, Y.; Dhalla, A.-H.; Huang, D. Blood Flow Velocity Quantification Using Split-Spectrum Amplitude-Decorrelation Angiography with Optical Coherence Tomography. Biomed. Opt. Express 2013, 4, 1909–1924. [Google Scholar] [CrossRef]
- Chen, T.-H.; Wu, Y.-C.; Tsai, T.-Y.; Chueh, C.-B.; Huang, B.-H.; Huang, Y.-P.; Tsai, M.-T.; Yasuno, Y.; Lee, H.-C. Effect of A-Scan Rate and Interscan Interval on Optical Coherence Angiography. Biomed. Opt. Express 2021, 12, 722–736. [Google Scholar] [CrossRef] [PubMed]
- Cole, E.D.; Moult, E.M.; Dang, S.; Choi, W.; Ploner, S.B.; Lee, B.; Louzada, R.; Novais, E.; Schottenhamml, J.; Husvogt, L.; et al. The Definition, Rationale, and Effects of Thresholding in OCT Angiography. Ophthalmol. Retin. 2017, 1, 435–447. [Google Scholar] [CrossRef] [PubMed]
- Ghasemi Falavarjani, K.; Al-Sheikh, M.; Akil, H.; Sadda, S.R. Image Artefacts in Swept-Source Optical Coherence Tomography Angiography. Br. J. Ophthalmol. 2017, 101, 564–568. [Google Scholar] [CrossRef]
- Vyawahare, H.; Shinde, P. Age-Related Macular Degeneration: Epidemiology, Pathophysiology, Diagnosis, and Treatment. Cureus 2022, 14, e29583. [Google Scholar] [CrossRef]
- Li, J.Q.; Welchowski, T.; Schmid, M.; Mauschitz, M.M.; Holz, F.G.; Finger, R.P. Prevalence and Incidence of Age-Related Macular Degeneration in Europe: A Systematic Review and Meta-Analysis. Br. J. Ophthalmol. 2020, 104, 1077–1084. [Google Scholar] [CrossRef]
- Rein, D.B.; Wittenborn, J.S.; Burke-Conte, Z.; Gulia, R.; Robalik, T.; Ehrlich, J.R.; Lundeen, E.A.; Flaxman, A.D. Prevalence of Age-Related Macular Degeneration in the US in 2019. JAMA Ophthalmol. 2022, 140, 1202–1208. [Google Scholar] [CrossRef] [PubMed]
- Wong, W.L.; Su, X.; Li, X.; Cheung, C.M.G.; Klein, R.; Cheng, C.-Y.; Wong, T.Y. Global Prevalence of Age-Related Macular Degeneration and Disease Burden Projection for 2020 and 2040: A Systematic Review and Meta-Analysis. Lancet Glob. Health 2014, 2, e106–e116. [Google Scholar] [CrossRef] [PubMed]
- Thomas, C.J.; Mirza, R.G.; Gill, M.K. Age-Related Macular Degeneration. Med. Clin. N. Am. 2021, 105, 473–491. [Google Scholar] [CrossRef]
- Colijn, J.M.; Buitendijk, G.H.S.; Prokofyeva, E.; Alves, D.; Cachulo, M.L.; Khawaja, A.P.; Cougnard-Gregoire, A.; Merle, B.M.J.; Korb, C.; Erke, M.G.; et al. Prevalence of Age-Related Macular Degeneration in Europe: The Past and the Future. Ophthalmology 2017, 124, 1753–1763. [Google Scholar] [CrossRef]
- Df, M.; Mg, M.; Gs, Y.; Je, G.; Sl, F.; Gj, J. Ranibizumab and Bevacizumab for Neovascular Age-Related Macular Degeneration. New Engl. J. Med. 2011, 364, 1897–1908. [Google Scholar] [CrossRef]
- Klein, R.; Klein, B.E.K.; Knudtson, M.D.; Meuer, S.M.; Swift, M.; Gangnon, R.E. Fifteen-Year Cumulative Incidence of Age-Related Macular Degeneration: The Beaver Dam Eye Study. Ophthalmology 2007, 114, 253–262. [Google Scholar] [CrossRef] [PubMed]
- Cohen, S.Y.; Dubois, L.; Tadayoni, R.; Delahaye-Mazza, C.; Debibie, C.; Quentel, G. Prevalence of Reticular Pseudodrusen in Age-Related Macular Degeneration with Newly Diagnosed Choroidal Neovascularisation. Br. J. Ophthalmol. 2007, 91, 354–359. [Google Scholar] [CrossRef] [PubMed]
- Abdolrahimzadeh, S.; Di Pippo, M.; Sordi, E.; Zweifel, S.A. Inner Retinal Layer Thickness Alterations in Early Age Related Macular Degeneration in Eyes with Subretinal Drusenoid Deposits or Conventional Drusen. J. Clin. Med. 2021, 10, 5136. [Google Scholar] [CrossRef] [PubMed]
- Schultz, N.M.; Bhardwaj, S.; Barclay, C.; Gaspar, L.; Schwartz, J. Global Burden of Dry Age-Related Macular Degeneration: A Targeted Literature Review. Clin. Ther. 2021, 43, 1792–1818. [Google Scholar] [CrossRef] [PubMed]
- Faatz, H.; Rothaus, K.; Ziegler, M.; Book, M.; Heimes-Bussmann, B.; Pauleikhoff, D.; Lommatzsch, A. Vascular Analysis of Type 1, 2, and 3 Macular Neovascularization in Age-Related Macular Degeneration Using Swept-Source Optical Coherence Tomography Angiography Shows New Insights into Differences of Pathologic Vasculature and May Lead to a More Personalized Understanding. Biomedicines 2022, 10, 694. [Google Scholar] [CrossRef] [PubMed]
- Anantharaman, G.; Sheth, J.; Bhende, M.; Narayanan, R.; Natarajan, S.; Rajendran, A.; Manayath, G.; Sen, P.; Biswas, R.; Banker, A.; et al. Polypoidal Choroidal Vasculopathy: Pearls in Diagnosis and Management. Indian J. Ophthalmol. 2018, 66, 896–908. [Google Scholar] [CrossRef]
- Ferris, F.L.; Wilkinson, C.P.; Bird, A.; Chakravarthy, U.; Chew, E.; Csaky, K.; Sadda, S.R.; Beckman Initiative for Macular Research Classification Committee. Clinical Classification of Age-Related Macular Degeneration. Ophthalmology 2013, 120, 844–851. [Google Scholar] [CrossRef]
- Grunwald, J.E.; Hariprasad, S.M.; DuPont, J.; Maguire, M.G.; Fine, S.L.; Brucker, A.J.; Maguire, A.M.; Ho, A.C. Foveolar Choroidal Blood Flow in Age-Related Macular Degeneration. Investig. Ophthalmol. Vis. Sci. 1998, 39, 385–390. [Google Scholar]
- Spaide, R.F. Enhanced Depth Imaging Optical Coherence Tomography of Retinal Pigment Epithelial Detachment in Age-Related Macular Degeneration. Am. J. Ophthalmol. 2009, 147, 644–652. [Google Scholar] [CrossRef]
- Rahman, W.; Chen, F.K.; Yeoh, J.; da Cruz, L. Enhanced Depth Imaging of the Choroid in Patients with Neovascular Age-Related Macular Degeneration Treated with Anti-VEGF Therapy versus Untreated Patients. Graefes Arch. Clin. Exp. Ophthalmol. 2013, 251, 1483–1488. [Google Scholar] [CrossRef]
- McLeod, D.S.; Grebe, R.; Bhutto, I.; Merges, C.; Baba, T.; Lutty, G.A. Relationship between RPE and Choriocapillaris in Age-Related Macular Degeneration. Investig. Ophthalmol. Vis. Sci. 2009, 50, 4982–4991. [Google Scholar] [CrossRef]
- Friedman, E. The Pathogenesis of Age-Related Macular Degeneration. Am. J. Ophthalmol. 2008, 146, 348–349. [Google Scholar] [CrossRef] [PubMed]
- Biesemeier, A.; Taubitz, T.; Julien, S.; Yoeruek, E.; Schraermeyer, U. Choriocapillaris Breakdown Precedes Retinal Degeneration in Age-Related Macular Degeneration. Neurobiol. Aging 2014, 35, 2562–2573. [Google Scholar] [CrossRef] [PubMed]
- Li, M.; Huisingh, C.; Messinger, J.; Dolz-Marco, R.; Ferrara, D.; Freund, K.B.; Curcio, C.A. Histology of geographic atrophy secondary to age-related macular degeneration: A multilayer approach. Retina 2018, 38, 1937–1953. [Google Scholar] [CrossRef]
- Zhou, H.; Dai, Y.; Shi, Y.; Russell, J.F.; Lyu, C.; Noorikolouri, J.; Feuer, W.J.; Chu, Z.; Zhang, Q.; de Sisternes, L.; et al. Age-Related Changes in Choroidal Thickness and the Volume of Vessels and Stroma Using Swept-Source OCT and Fully Automated Algorithms. Ophthalmol. Retin. 2020, 4, 204–215. [Google Scholar] [CrossRef] [PubMed]
- Breher, K.; Terry, L.; Bower, T.; Wahl, S. Choroidal Biomarkers: A Repeatability and Topographical Comparison of Choroidal Thickness and Choroidal Vascularity Index in Healthy Eyes. Transl. Vis. Sci. Technol. 2020, 9, 8. [Google Scholar] [CrossRef]
- Wei, X.; Ting, D.S.W.; Ng, W.Y.; Khandelwal, N.; Agrawal, R.; Cheung, C.M.G. Choroidal vascularity index: A Novel Optical Coherence Tomography based Parameter in Patients with Exudative Age-Related Macular Degeneration. Retina 2017, 37, 1120–1125. [Google Scholar] [CrossRef]
- Giannaccare, G.; Pellegrini, M.; Sebastiani, S.; Bernabei, F.; Moscardelli, F.; Iovino, C.; Napoli, P.E.; Campos, E. Choroidal vascularity index quantification in geographic atrophy using binarization of enhanced-depth imaging optical coherence tomographic scans. Retina 2020, 40, 960–965. [Google Scholar] [CrossRef]
- Koh, L.H.L.; Agrawal, R.; Khandelwal, N.; Sai Charan, L.; Chhablani, J. Choroidal Vascular Changes in Age-Related Macular Degeneration. Acta Ophthalmol. 2017, 95, e597–e601. [Google Scholar] [CrossRef]
- Singh, S.R.; Oli, A.; Mohan, S.; Goud, A.; Rasheed, M.A.; Vupparaboina, K.K.; Chhablani, J.K. Pachydrusen in Indian Population: A Hospital-Based Study. Indian J. Ophthalmol. 2019, 67, 371–375. [Google Scholar] [CrossRef]
- Corvi, F.; Souied, E.H.; Capuano, V.; Costanzo, E.; Benatti, L.; Querques, L.; Bandello, F.; Querques, G. Choroidal Structure in Eyes with Drusen and Reticular Pseudodrusen Determined by Binarisation of Optical Coherence Tomographic Images. Br. J. Ophthalmol. 2017, 101, 348–352. [Google Scholar] [CrossRef] [PubMed]
- Abdolrahimzadeh, S.; Di Pippo, M.; Sordi, E.; Cusato, M.; Lotery, A.J. Subretinal Drusenoid Deposits as a Biomarker of Age-Related Macular Degeneration Progression via Reduction of the Choroidal Vascularity Index. Eye 2022, 37, 1365–1370. [Google Scholar] [CrossRef] [PubMed]
- Velaga, S.B.; Nittala, M.G.; Vupparaboina, K.K.; Jana, S.; Chhablani, J.; Haines, J.; Pericak-Vance, M.A.; Stambolian, D.; Sadda, S.R. Choroidal Vascularity Index and Choroidal Thickness in Eyes with Reticular Pseudodrusen. Retina 2020, 40, 612–617. [Google Scholar] [CrossRef]
- Sacconi, R.; Vella, G.; Battista, M.; Borrelli, E.; Balasubramanian, S.; Querques, L.; Bandello, F.; Querques, G. Choroidal Vascularity Index in Different Cohorts of Dry Age-Related Macular Degeneration. Transl. Vis. Sci. Technol. 2021, 10, 26. [Google Scholar] [CrossRef]
- Invernizzi, A.; Benatti, E.; Cozzi, M.; Erba, S.; Vaishnavi, S.; Vupparaboina, K.K.; Staurenghi, G.; Chhablani, J.; Gillies, M.; Viola, F. Choroidal Structural Changes Correlate with Neovascular Activity in Neovascular Age Related Macular Degeneration. Investig. Ophthalmol. Vis. Sci. 2018, 59, 3836. [Google Scholar] [CrossRef]
- Toto, L.; Ruggeri, M.L.; Evangelista, F.; Trivigno, C.; D’Aloisio, R.; De Nicola, C.; Viggiano, P.; Doronzo, E.; Di Nicola, M.; Porreca, A.; et al. Choroidal and Retinal Imaging Biomarkers in Different Types of Macular Neovascularization. J. Clin. Med. 2023, 12, 1140. [Google Scholar] [CrossRef] [PubMed]
- Borrelli, E.; Shi, Y.; Uji, A.; Balasubramanian, S.; Nassisi, M.; Sarraf, D.; Sadda, S.R. Topographic Analysis of the Choriocapillaris in Intermediate Age-Related Macular Degeneration. Am. J. Ophthalmol. 2018, 196, 34–43. [Google Scholar] [CrossRef]
- Corbelli, E.; Sacconi, R.; Rabiolo, A.; Mercuri, S.; Carnevali, A.; Querques, L.; Bandello, F.; Querques, G. Optical Coherence Tomography Angiography in the Evaluation of Geographic Atrophy Area Extension. Investig. Ophthalmol. Vis. Sci. 2017, 58, 5201–5208. [Google Scholar] [CrossRef]
- Mullins, R.F.; Johnson, M.N.; Faidley, E.A.; Skeie, J.M.; Huang, J. Choriocapillaris Vascular Dropout Related to Density of Drusen in Human Eyes with Early Age-Related Macular Degeneration. Investig. Ophthalmol. Vis. Sci. 2011, 52, 1606–1612. [Google Scholar] [CrossRef]
- Curcio, C.A.; Messinger, J.D.; Sloan, K.R.; McGwin, G.; Medeiros, N.E.; Spaide, R.F. Subretinal Drusenoid Deposits in Non-Neovascular Age-Related Macular Degeneration: Morphology, Prevalence, Topography, and Biogenesis Model. Retina 2013, 33, 265–276. [Google Scholar] [CrossRef]
- Li, J.; Liu, Z.; Lu, J.; Shen, M.; Cheng, Y.; Siddiqui, N.; Zhou, H.; Zhang, Q.; Liu, J.; Herrera, G.; et al. Decreased Macular Choriocapillaris Perfusion in Eyes with Macular Reticular Pseudodrusen Imaged with Swept-Source OCT Angiography. Investig. Ophthalmol. Vis. Sci. 2023, 64, 15. [Google Scholar] [CrossRef]
- Bhutto, I.; Lutty, G. Understanding Age-Related Macular Degeneration (AMD): Relationships between the Photoreceptor/Retinal Pigment Epithelium/Bruch’s Membrane/Choriocapillaris Complex. Mol. Asp. Med. 2012, 33, 295–317. [Google Scholar] [CrossRef]
- Nesper, P.L.; Soetikno, B.T.; Fawzi, A.A. Choriocapillaris Nonperfusion Is Associated with Poor Visual Acuity in Eyes with Reticular Pseudodrusen. Am. J. Ophthalmol. 2017, 174, 42–55. [Google Scholar] [CrossRef] [PubMed]
- Sacconi, R.; Corbelli, E.; Borrelli, E.; Capone, L.; Carnevali, A.; Gelormini, F.; Querques, L.; Bandello, F.; Querques, G. Choriocapillaris Flow Impairment Could Predict the Enlargement of Geographic Atrophy Lesion. Br. J. Ophthalmol. 2021, 105, 97–102. [Google Scholar] [CrossRef] [PubMed]
- Thulliez, M.; Zhang, Q.; Shi, Y.; Zhou, H.; Chu, Z.; de Sisternes, L.; Durbin, M.K.; Feuer, W.; Gregori, G.; Wang, R.K.; et al. Correlations between Choriocapillaris Flow Deficits around Geographic Atrophy and Enlargement Rates based on Swept-Source OCT Imaging. Ophthalmol. Retin. 2019, 3, 478–488. [Google Scholar] [CrossRef]
- Moult, E.M.; Waheed, N.K.; Novais, E.A.; Choi, W.; Lee, B.; Ploner, S.B.; Cole, E.D.; Louzada, R.N.; Lu, C.D.; Rosenfeld, P.J.; et al. Swept-source optical coherence tomography angiography reveals choriocapillaris alterations in eyes with nascent geographic atrophy and drusen-associated geographic atrophy. Retina 2016, 36 (Suppl. 1), S2–S11. [Google Scholar] [CrossRef] [PubMed]
- Borrelli, E.; Sarraf, D.; Freund, K.B.; Sadda, S.R. OCT Angiography and Evaluation of the Choroid and Choroidal Vascular Disorders. Prog. Retin. Eye Res. 2018, 67, 30–55. [Google Scholar] [CrossRef]
- Viggiano, P.; Grassi, M.O.; Pignataro, M.; Boscia, G.; Borrelli, E.; Molfetta, T.; Evangelista, F.; Alessio, G.; Boscia, F. Topographical Analysis of the Choriocapillaris Reperfusion after Loading Anti-VEGF Therapy in Neovascular AMD. Transl. Vis. Sci. Technol. 2022, 11, 18. [Google Scholar] [CrossRef]
- Cabral, D.; Fradinho, A.C.; Zhang, Y.; Zhou, H.; Ramtohul, P.; Ramakrishnan, M.S.; Pereira, T.; Wang, R.K.; Freund, K.B. Quantitative Assessment of Choriocapillaris Flow Deficits and Type 1 Macular Neovascularization Growth in Age-Related Macular Degeneration. Sci. Rep. 2023, 13, 8572. [Google Scholar] [CrossRef]

| Parameter | Advantages | Disadvantages |
|---|---|---|
| CVI |
|
|
| OCTA |
|
|
Disclaimer/Publisher’s Note: The statements, opinions and data contained in all publications are solely those of the individual author(s) and contributor(s) and not of MDPI and/or the editor(s). MDPI and/or the editor(s) disclaim responsibility for any injury to people or property resulting from any ideas, methods, instructions or products referred to in the content. |
© 2023 by the authors. Licensee MDPI, Basel, Switzerland. This article is an open access article distributed under the terms and conditions of the Creative Commons Attribution (CC BY) license (https://creativecommons.org/licenses/by/4.0/).
Share and Cite
Di Pippo, M.; Santia, C.; Rullo, D.; Ciancimino, C.; Grassi, F.; Abdolrahimzadeh, S. The Choroidal Vascularity Index Versus Optical Coherence Tomography Angiography in the Evaluation of the Choroid with a Focus on Age-Related Macular Degeneration. Tomography 2023, 9, 1456-1470. https://doi.org/10.3390/tomography9040116
Di Pippo M, Santia C, Rullo D, Ciancimino C, Grassi F, Abdolrahimzadeh S. The Choroidal Vascularity Index Versus Optical Coherence Tomography Angiography in the Evaluation of the Choroid with a Focus on Age-Related Macular Degeneration. Tomography. 2023; 9(4):1456-1470. https://doi.org/10.3390/tomography9040116
Chicago/Turabian StyleDi Pippo, Mariachiara, Claudia Santia, Daria Rullo, Chiara Ciancimino, Flaminia Grassi, and Solmaz Abdolrahimzadeh. 2023. "The Choroidal Vascularity Index Versus Optical Coherence Tomography Angiography in the Evaluation of the Choroid with a Focus on Age-Related Macular Degeneration" Tomography 9, no. 4: 1456-1470. https://doi.org/10.3390/tomography9040116
APA StyleDi Pippo, M., Santia, C., Rullo, D., Ciancimino, C., Grassi, F., & Abdolrahimzadeh, S. (2023). The Choroidal Vascularity Index Versus Optical Coherence Tomography Angiography in the Evaluation of the Choroid with a Focus on Age-Related Macular Degeneration. Tomography, 9(4), 1456-1470. https://doi.org/10.3390/tomography9040116






